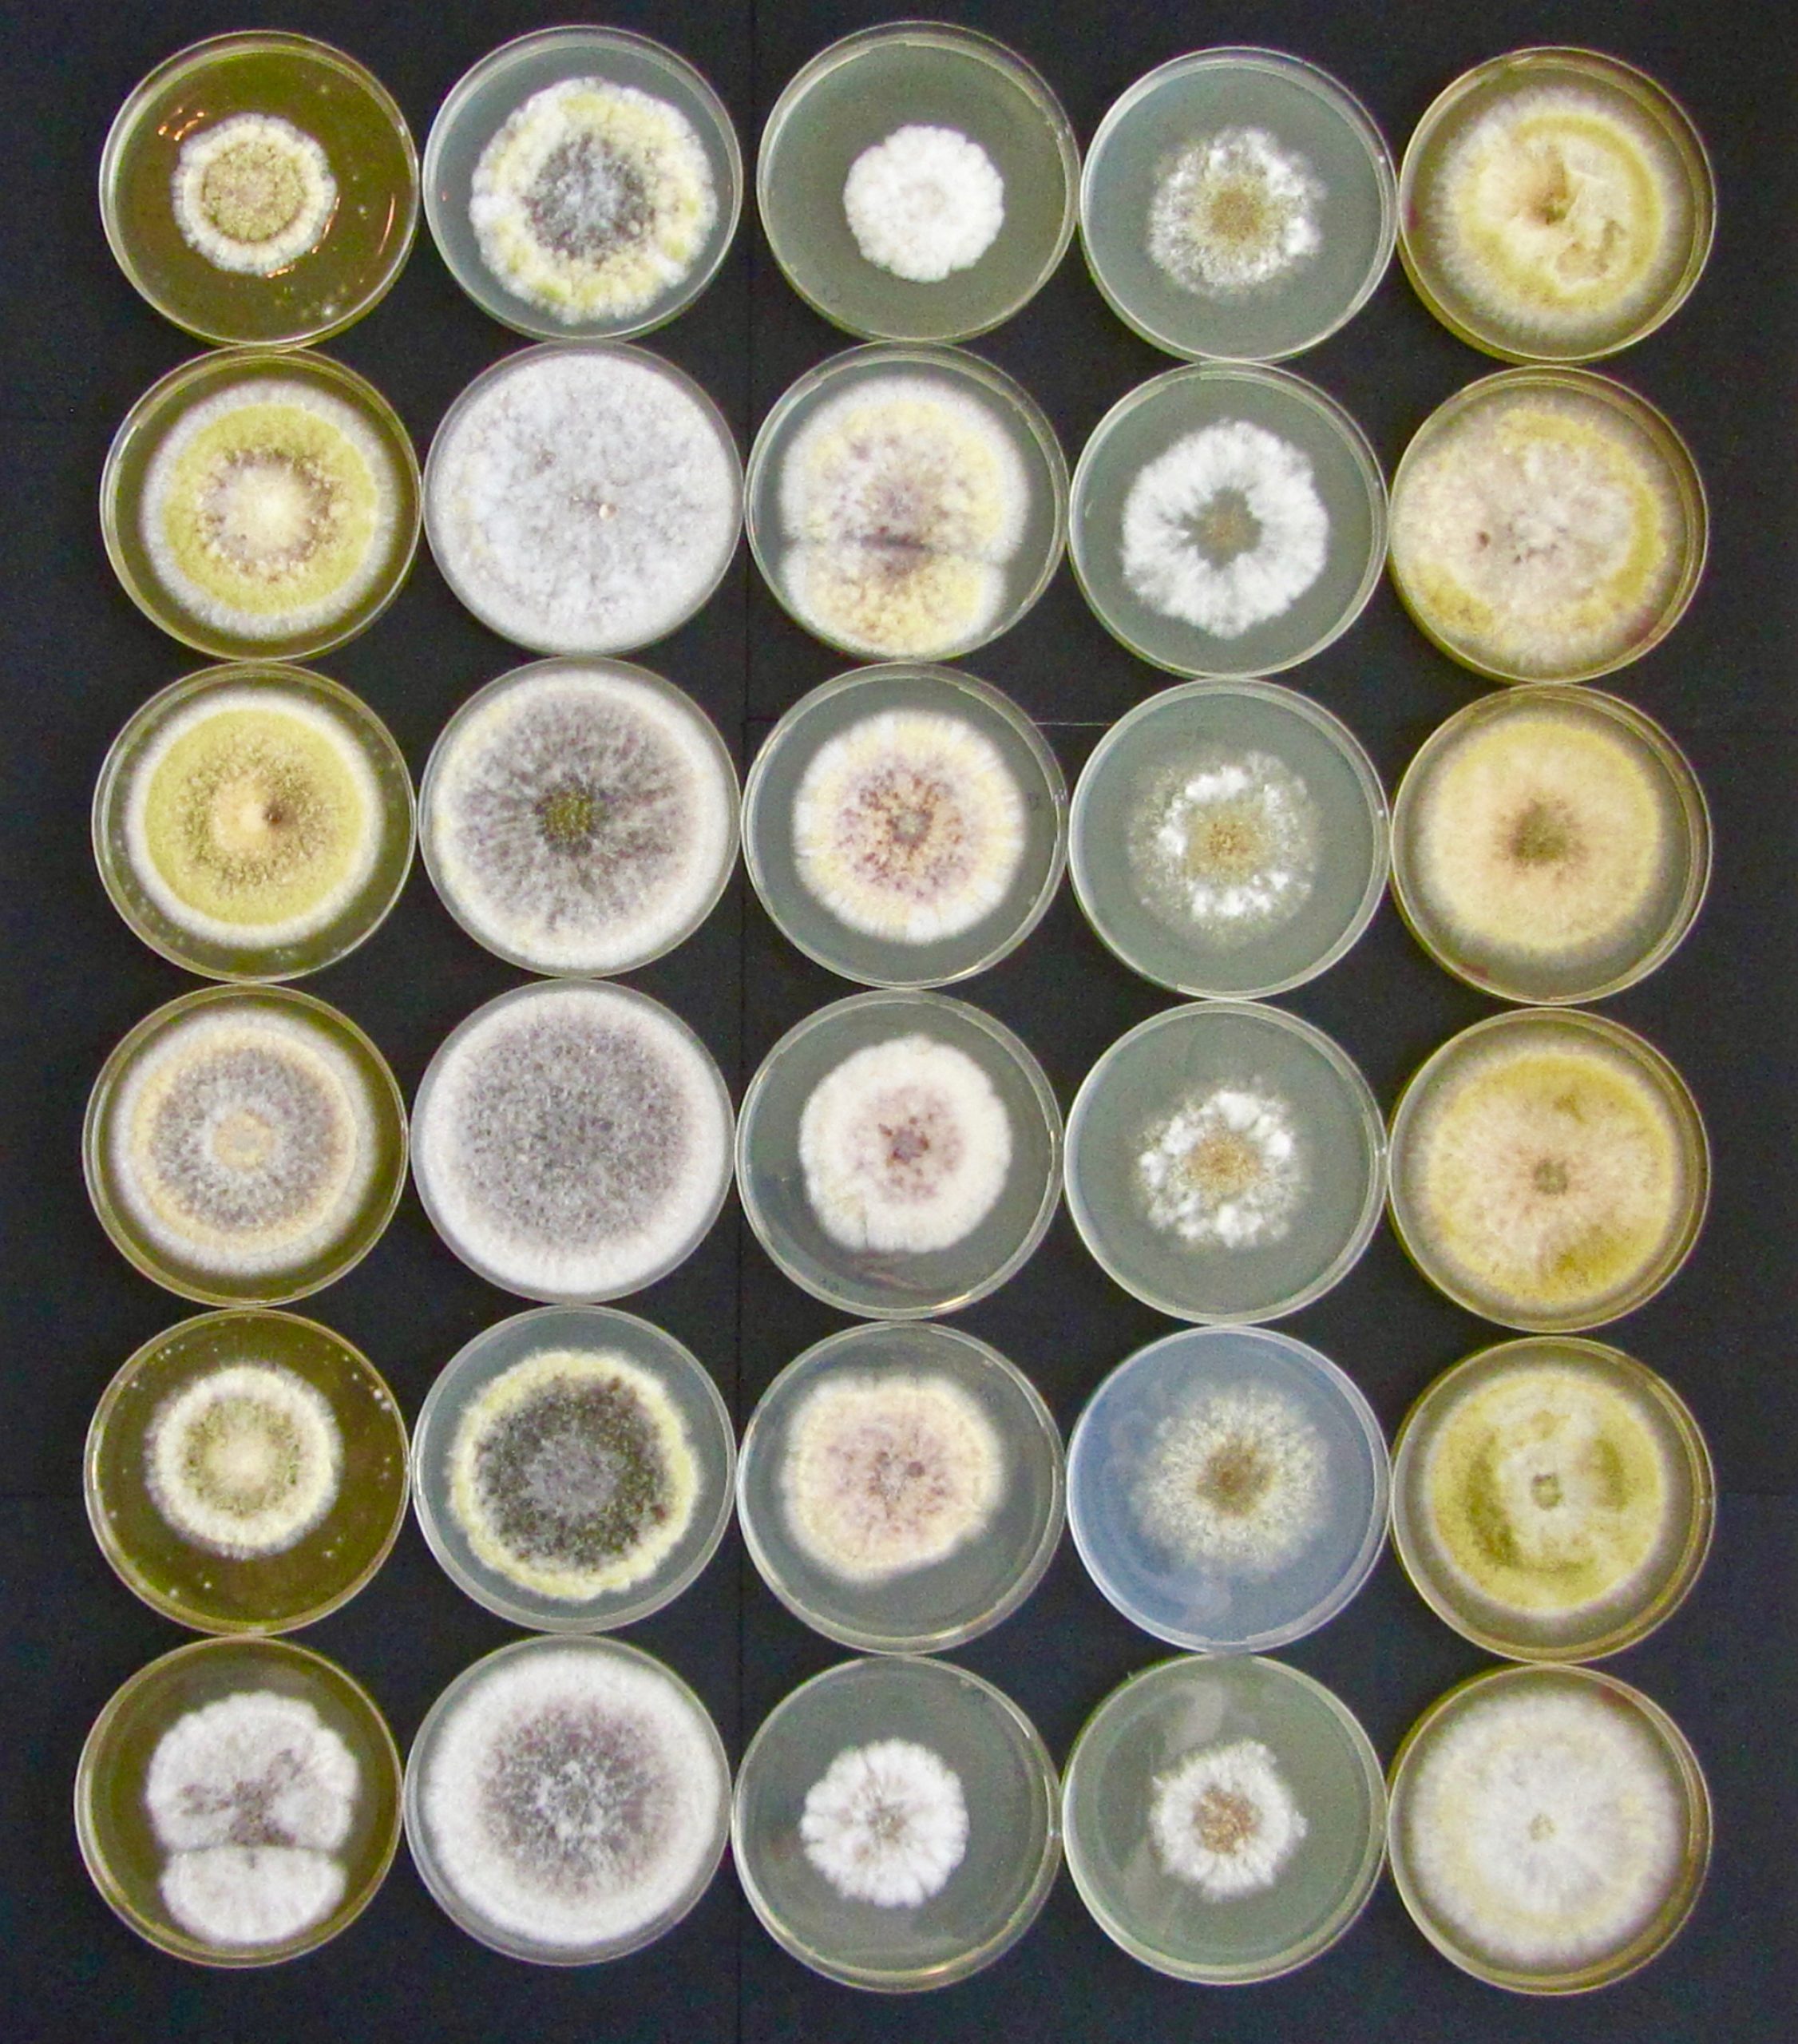
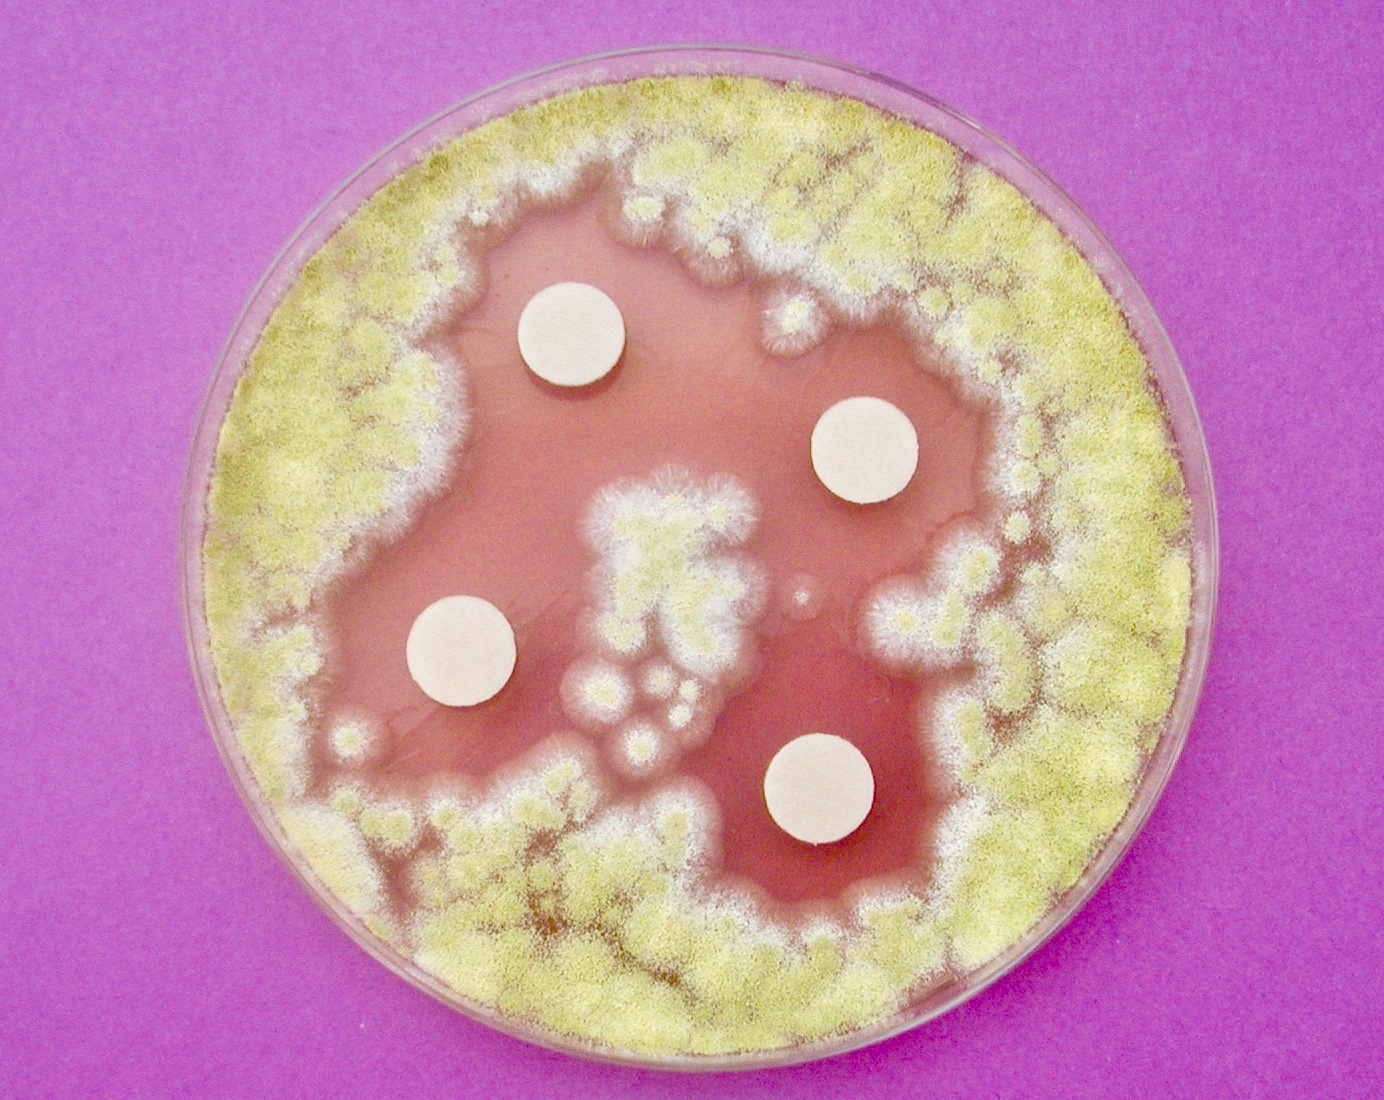

Autres services

R&D
◾ Screening de molécules à activité fongicide / fongistatique sur différentes espèces en fonction du domaine d’application
◾ Aide au développement et à la validation de méthodes rapides d’analyse (identification d’espèce ou détection de la contamination) …
Nous contacterParticipation à des projets de recherche
◾ Caractérisation morphologique de souches (mutants, nouvelles espèces, impact de différents paramètres sur la morphologie…)
◾ Étude de la biodiversité fongique de tout substrat
◾ Isolement et fourniture de souches d’intérêt à partir de tout substrat
Nous contacterFormations et veille scientifique
◾ MYCOSCOPIA peut proposer des formations et de la veille scientifique dans le domaine de la contamination fongique/mycotoxique des aliments et son impact sur la santé des animaux (approche par type d’aliments, par filières de production…).
Nous contacter